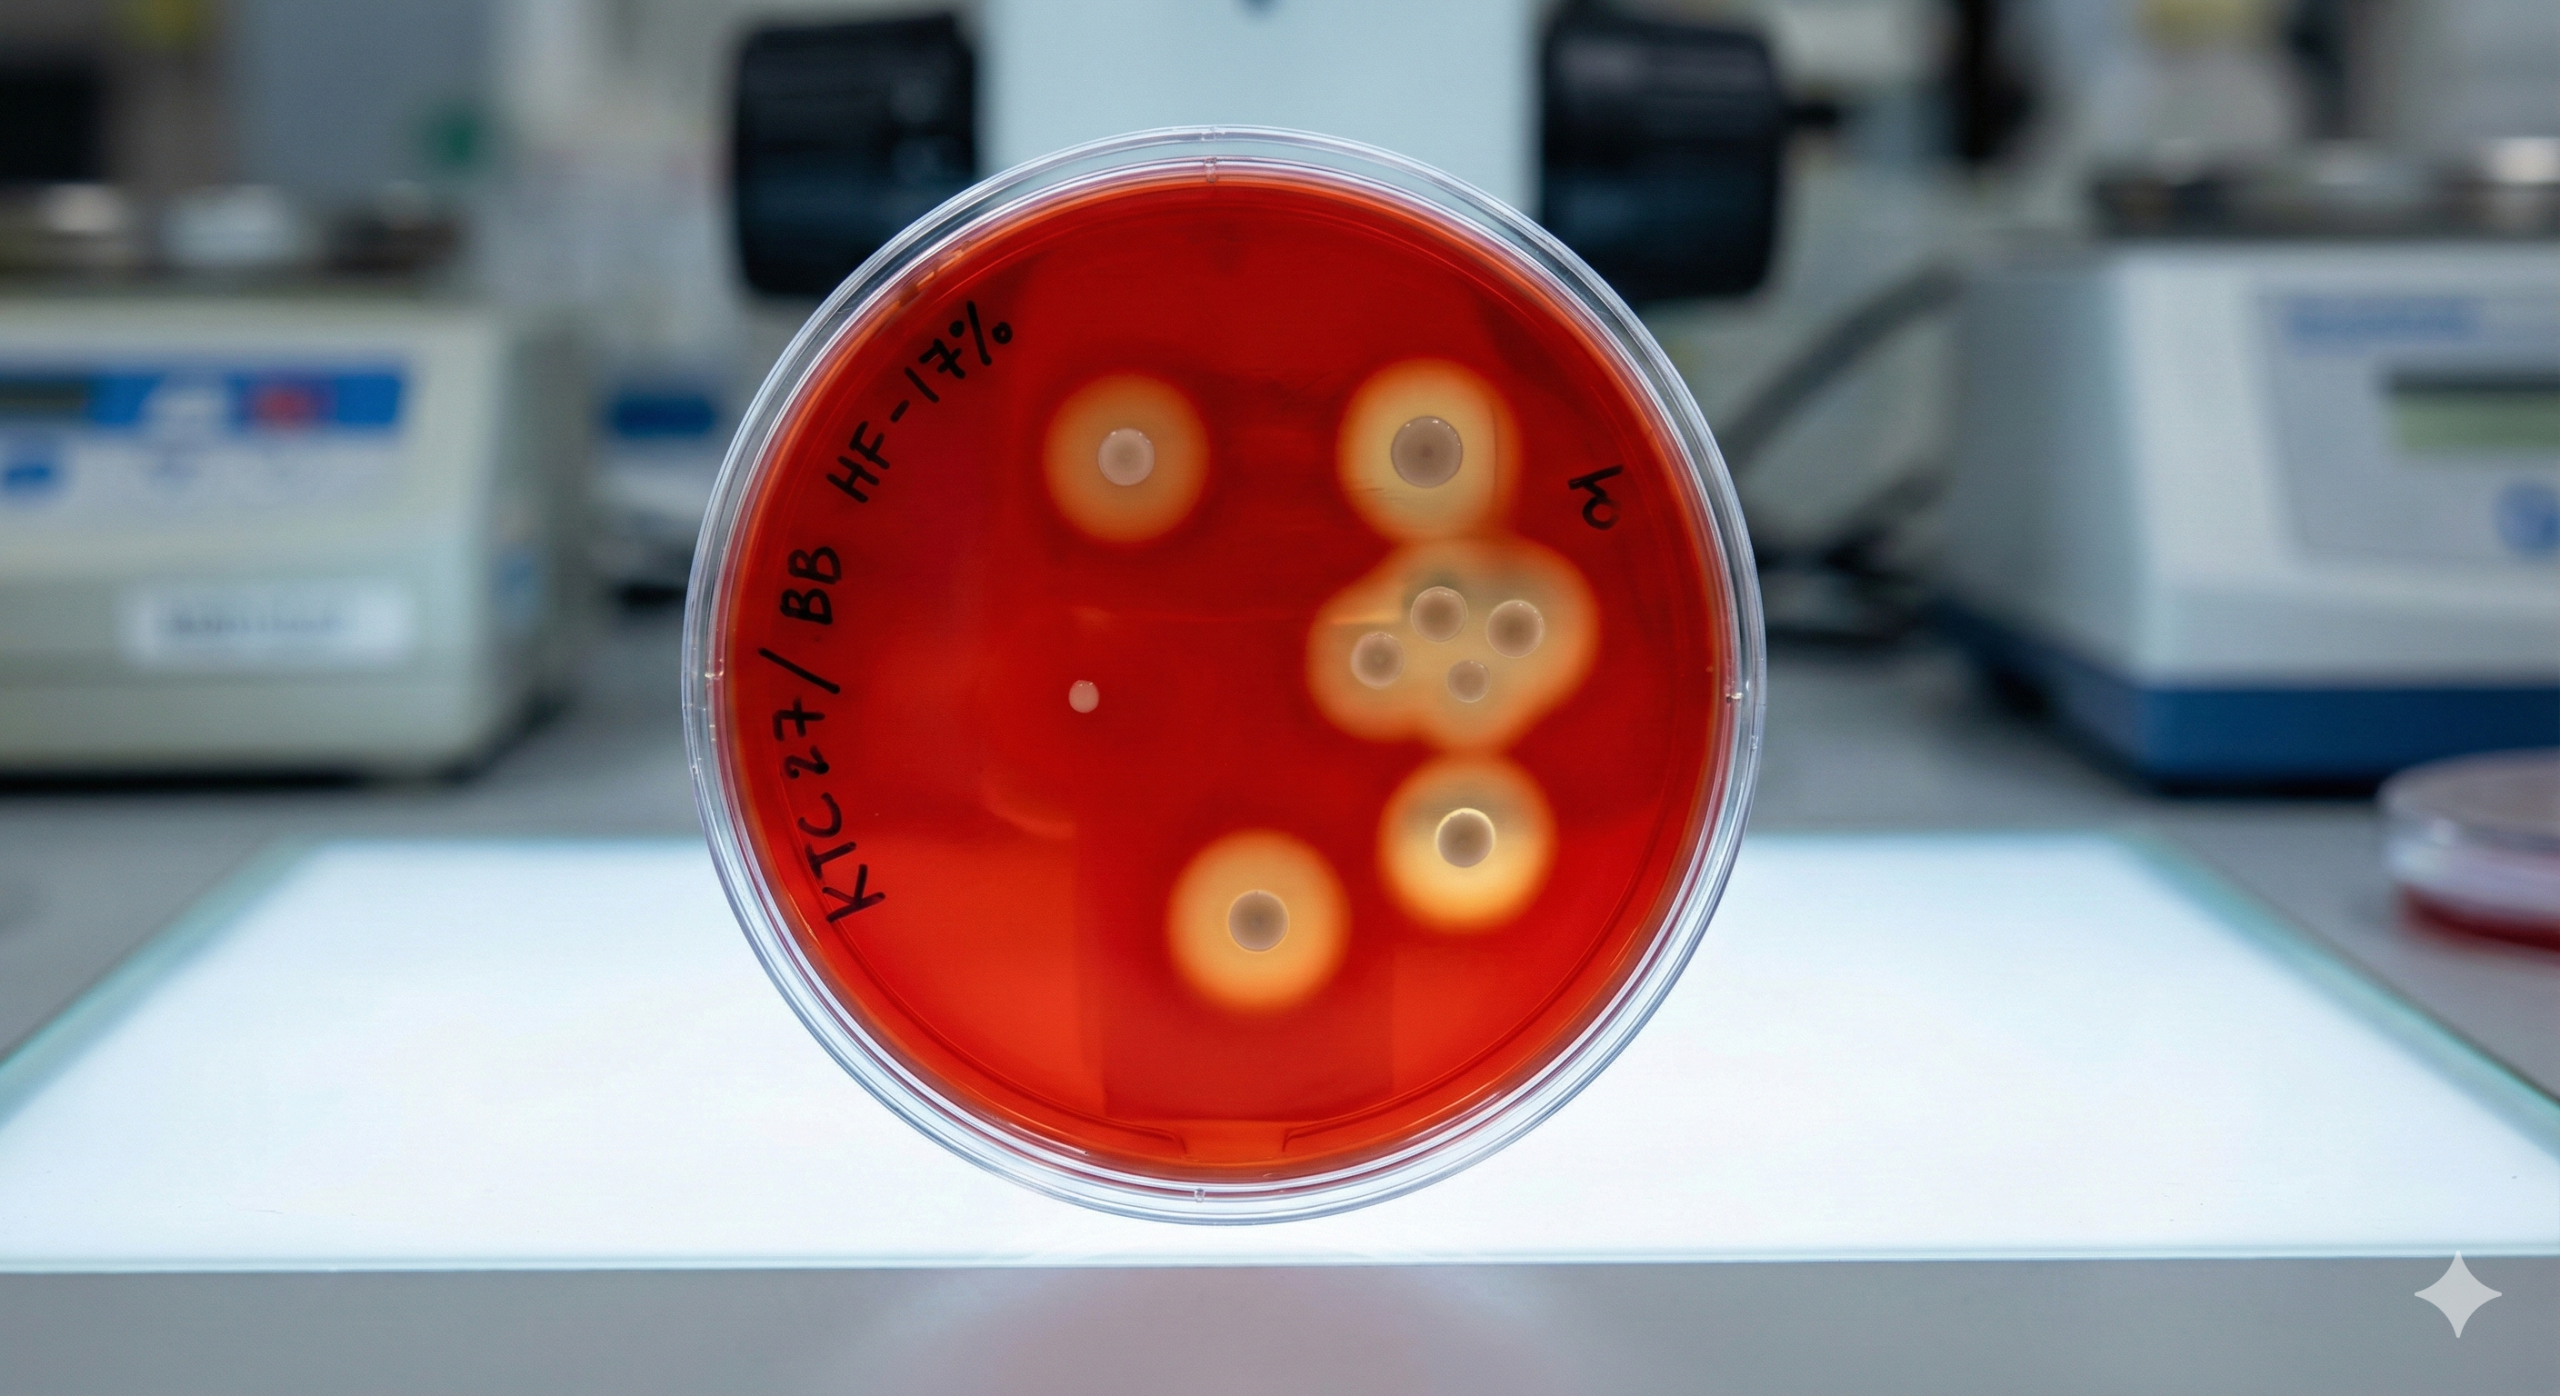
Bán môi trường thạch máu BA tại Cần Thơ: hàng có sẵn

Bán môi trường thạch máu BA tại Cần Thơ uy tín, đảm bảo chất lượng vi sinh và đặc biệt là hàng luôn có sẵn là nhu cầu cấp thiết của nhiều phòng xét nghiệm, bệnh viện và các trung tâm nghiên cứu tại khu vực Đồng bằng sông Cửu Long. Môi trường nuôi cấy vi khuẩn đòi hỏi điều kiện bảo quản khắt khe và thời gian sử dụng ngắn, do đó, việc có nguồn cung tại chỗ sẽ giải quyết được bài toán về thời gian và chất lượng mẫu.
Bài viết này sẽ cung cấp thông tin chi tiết về địa chỉ cung cấp đĩa thạch máu (Blood Agar) chất lượng cao ngay tại Cần Thơ để phục vụ công tác xét nghiệm của bạn.
1. Tầm quan trọng của môi trường thạch máu (Blood Agar) trong xét nghiệm
Trước khi tìm hiểu về nơi bán môi trường thạch máu BA tại Cần Thơ, chúng ta cần nắm rõ tiêu chuẩn kỹ thuật của loại môi trường này. Thạch máu (Blood Agar – BA) là môi trường không chọn lọc, giàu dinh dưỡng, được bổ sung máu động vật (thường là máu cừu hoặc máu ngựa) để nuôi cấy nhiều loại vi khuẩn khó tính (fastidious bacteria).
Một đĩa thạch máu đạt chuẩn phải giúp kỹ thuật viên xác định được tính chất tan máu (hemolysis) của vi khuẩn:
- ✓ Tan máu Alpha (α): Vi khuẩn oxy hóa hemoglobin tạo ra vòng màu xanh lục xung quanh khuẩn lạc (ví dụ: Streptococcus pneumoniae).
- ✓ Tan máu Beta (β): Vi khuẩn làm tan hoàn toàn hồng cầu, tạo ra vòng trong suốt xung quanh khuẩn lạc (ví dụ: Streptococcus pyogenes).
- ✓ Tan máu Gamma (γ): Không gây tan máu (ví dụ: Enterococcus faecalis).
Chính vì tính chất phức tạp này, nguồn cung cấp thạch phải đảm bảo quy trình sản xuất vô trùng tuyệt đối, máu sử dụng phải sạch và tươi mới.
2. Tại sao nên mua môi trường thạch máu BA tại Cần Thơ thay vì đặt từ xa?
Nhiều đơn vị thường đặt mua môi trường từ TP. Hồ Chí Minh hoặc Hà Nội. Tuy nhiên, với đặc thù của hàng sinh phẩm, việc vận chuyển đường dài mang lại nhiều rủi ro:
- Rủi ro về nhiệt độ: Thạch máu cần bảo quản lạnh (2-8°C). Quá trình vận chuyển không đảm bảo nhiệt độ có thể làm hỏng bề mặt thạch, gây khô hoặc nhiễm khuẩn ngoại lai.
- Rủi ro va đập: Đĩa Petri dễ bị vỡ hoặc bung nắp trong quá trình giao hàng, gây mất an toàn sinh học.
- Thời gian chờ đợi: Khi phòng Lab cần gấp để cấy mẫu bệnh phẩm, việc chờ đợi 2-3 ngày vận chuyển là không khả thi.
Do đó, giải pháp tối ưu nhất là tìm đơn vị bán môi trường thạch máu BA tại Cần Thơ có kho hàng tại chỗ để giao nhận ngay trong ngày.
3. NP Duy Lab – Địa chỉ bán môi trường thạch máu BA tại Cần Thơ uy tín
Nếu bạn đang tìm kiếm nguồn vật tư y tế và hóa chất xét nghiệm tin cậy, NP Duy Lab là đối tác hàng đầu tại khu vực Cần Thơ và Miền Tây. Chúng tôi chuyên cung cấp vật tư hóa chất, giải pháp phần mềm cho phòng xét nghiệm với cam kết chất lượng cao nhất.
Ưu điểm khi mua môi trường vi sinh tại NP Duy Lab:
Chúng tôi hiểu rõ những khó khăn của Kỹ thuật viên vi sinh, do đó sản phẩm cung cấp luôn đảm bảo:
- Hàng có sẵn (Stock): Luôn duy trì số lượng ổn định tại kho Cần Thơ, đáp ứng ngay lập tức các đơn hàng gấp.
- Date mới liên tục: Vì là hàng sinh phẩm có hạn sử dụng ngắn, chúng tôi nhập và luân chuyển hàng liên tục, đảm bảo khách hàng không nhận phải hàng cận date.
- Bề mặt thạch đẹp: Đĩa thạch dày dặn, bề mặt mịn, không bọt khí, màu đỏ tươi chuẩn của máu cừu/ngựa, giúp khuẩn lạc mọc điển hình.
- Vô trùng tuyệt đối: Quy trình đóng gói kín, kiểm soát nhiễm khuẩn chặt chẽ.
Các loại môi trường khác ngoài Thạch máu (BA)
Bên cạnh việc bán môi trường thạch máu BA tại Cần Thơ, chúng tôi còn cung cấp đầy đủ các loại môi trường nuôi cấy khác như:
- Môi trường MacConkey (MC).
- Môi trường Chocolate (CA).
- Môi trường CLED (nuôi cấy nước tiểu).
- Môi trường Mueller-Hinton (làm kháng sinh đồ).
- Các loại ống nghiệm, đĩa Petri, que cấy và vật tư tiêu hao khác.
4. Thông tin liên hệ mua hàng và tư vấn kỹ thuật
Để nhận báo giá tốt nhất và được tư vấn kỹ thuật về cách sử dụng, bảo quản môi trường nuôi cấy, quý khách hàng vui lòng liên hệ trực tiếp với Nguyễn Phúc Duy. Chúng tôi không chỉ bán sản phẩm, mà còn mang đến giải pháp tối ưu cho quy trình vận hành phòng Lab của bạn.
LIÊN HỆ ĐẶT HÀNG NGAY HÔM NAY
Chuyên gia: Nguyễn Phúc Duy
Điện thoại / Zalo: 0869.931.949
Website: npduylab.com
Chuyên cung cấp vật tư hóa chất, giải pháp phần mềm cho phòng xét nghiệm tại Cần Thơ và Miền Tây.
Hy vọng bài viết này đã giúp bạn tìm được địa chỉ bán môi trường thạch máu BA tại Cần Thơ ưng ý. Đừng để quy trình xét nghiệm bị gián đoạn vì thiếu vật tư, hãy liên hệ ngay với NP Duy Lab để được phục vụ nhanh chóng nhất!